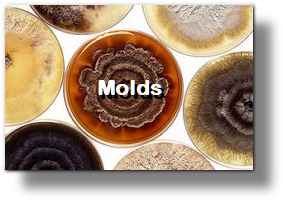

|
|



En sinusitis alérgica micótica, los anticuerpos de moho específica son elevados. Aunque la sinusitis alérgica
micótica impica mecanismos mediados de Inmunoglobulina E (IgE), no todos los pacientes diagnosticados
demuestran serología IgE específica o pruebas cutáneas. Los IgG específica elevados de moho se detectan con
regularidad más que IgE específica y pueden ser de gran valor diagnóstico en la evaluación de la sinusitis
micótica.
Alternaria alternata
Aspergillus fumigatus
Cándida albicans
Cladosporium herbarum
Curvularia lunata
Epiccocum nigrum
Fusarium oxysporum
Helminthosporium halodes
Mucor racemosus
Penicillium notatum
Phoma betae
Pullularia pullulans
Rhizopus nigricans
Stemphyllium botryosum
Alternaria alternata
Aspergillus fumigatus
Cándida albicans
Cladosporium herbarum
Curvularia lunata
Epiccocum nigrum
Fusarium oxysporum
Helminthosporium halodes
Mucor racemosus
Penicillium notatum
Phoma betae
Pullularia pullulans
Rhizopus nigricans
Stemphyllium botryosum
Mejorando la respuesta alérgica
400 Sugartree Lane*Suite510*Franklin*TN*37064
Tel 615-599-4100 * Fax 615-599-4648